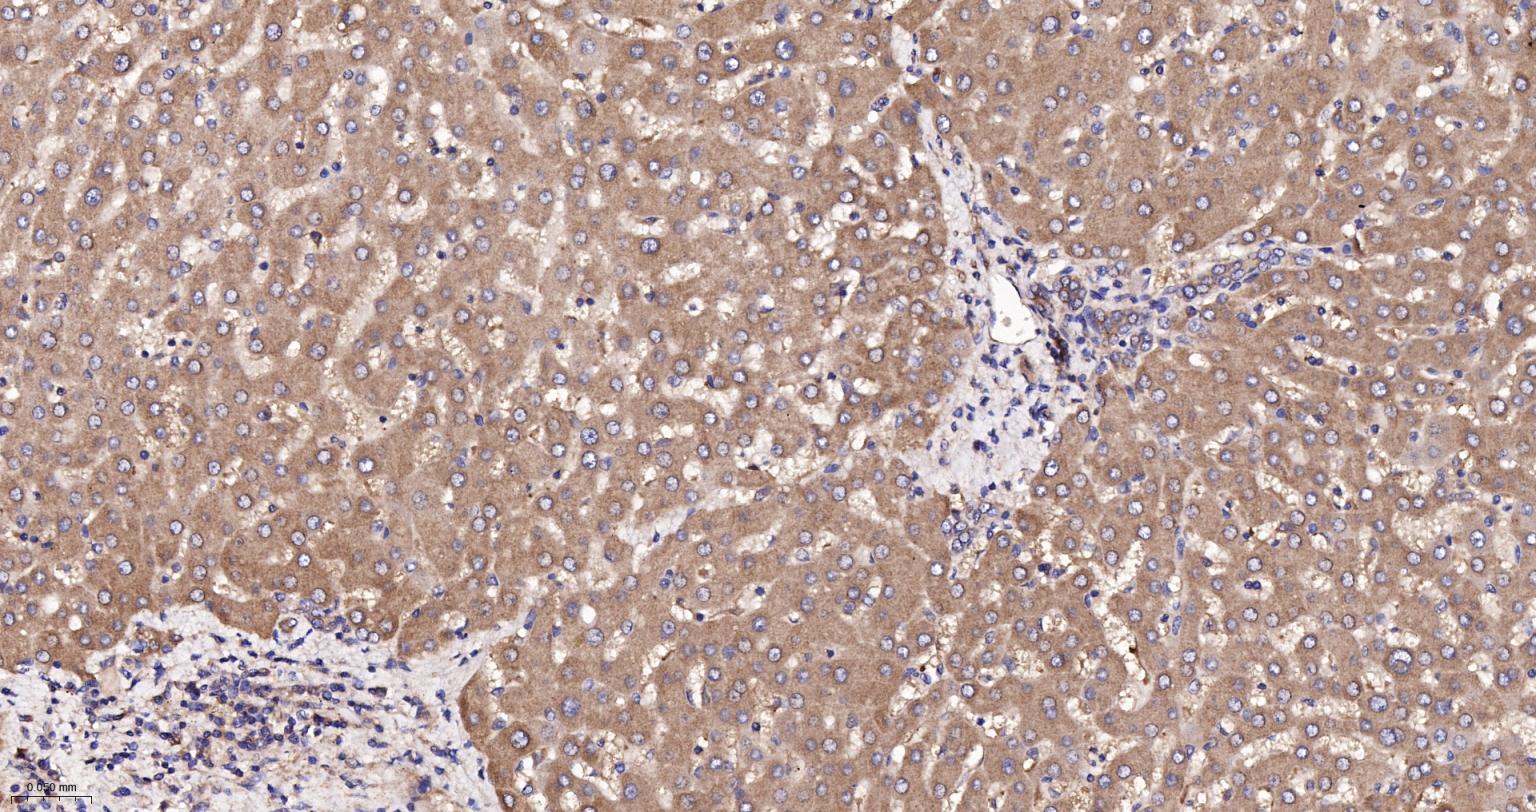
GADD153重组兔单抗
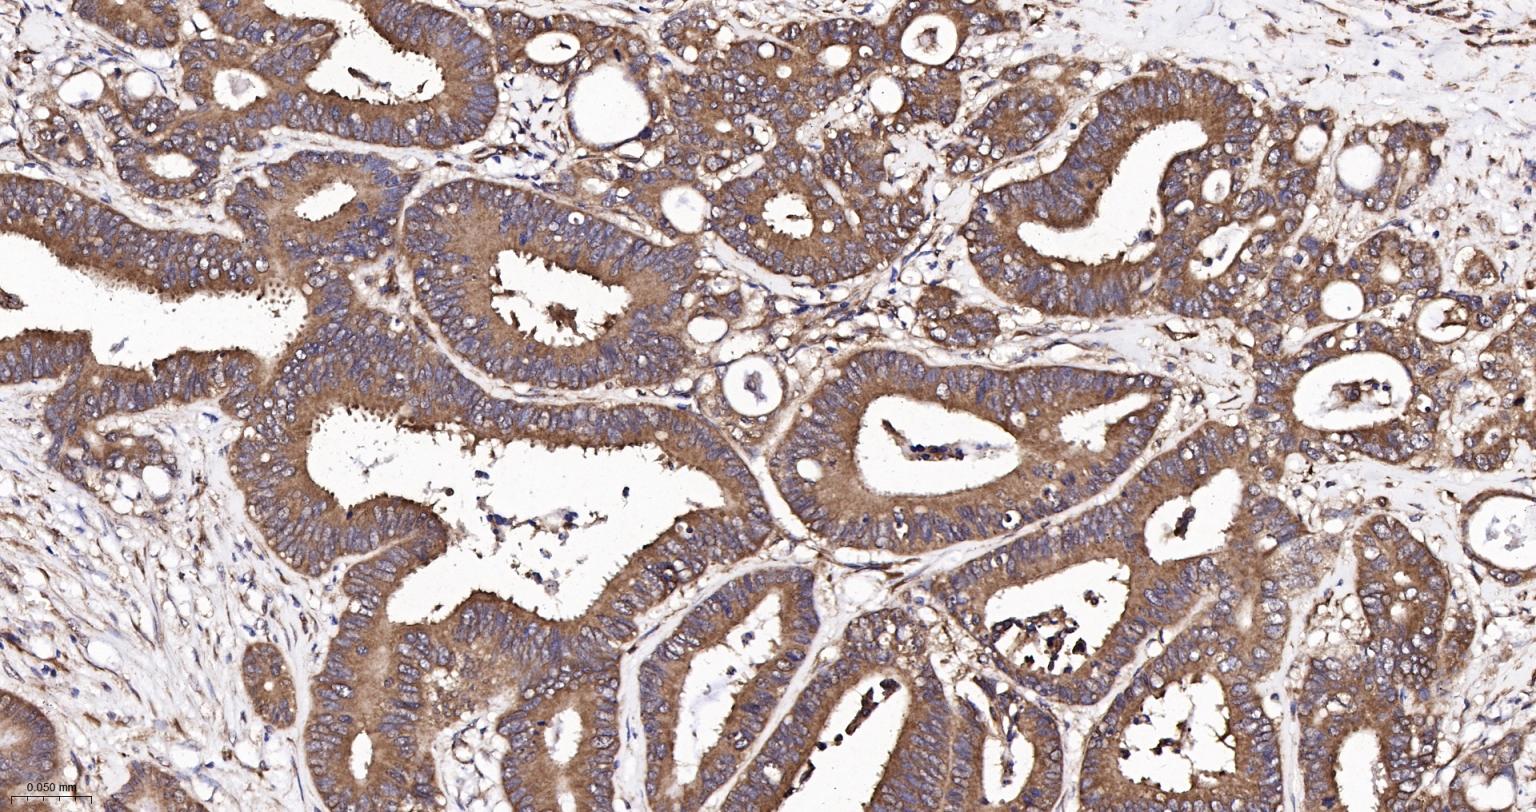
GADD153重组兔单抗

DDIT3 Recombinant Rabbit mAb (一抗) - WB,IHC-P,IHC-F,IF | Bioss
Rrmab?兔单抗

货号:bsm-52881R
产品详情
相关标记
相关产品
相关文献
常见问题
概述
产品编号
bsm-52881R
产品类型
重组兔单抗、mIHC精品抗体
英文名称
DDIT3 Recombinant Rabbit mAb
中文名称
GADD153重组兔单抗
英文别名
AltDDIT3; C/EBPzeta; CEBPZ; CHOP; CHOP-10; CHOP10; GADD153; RM4; DDIT3_HUMAN; DDIT3; DDIT-3; C/EBP zeta; C/EBP-homologous protein (CHOP); C/EBP-homologous protein 10 (CHOP-10); CCAAT/enhancer-binding protein homologous protein; Growth arrest and DNA damage-inducible protein GADD153; DDIT3_MOUSE; Growth arrest and DNA-damage-inducible protein GADD153; DDIT3_RAT;
抗体来源
Rabbit
免疫原
A synthesized peptide derived from human DDIT3: 140-169
亚型
IgG
性状
Liquid
纯化方法
affinity purified by Protein A
克隆类型
Recombinant
克隆号
6C8
理论分子量
19 kDa
检测分子量
28 kDa
浓度
1mg/ml
储存液
0.01M TBS (pH7.4) with 1% BSA, 0.02% Proclin300 and 50% Glycerol.
研究领域
SWISS
Gene ID
保存条件
Shipped at 4℃. Store at -20℃ for one year. Avoid repeated freeze/thaw cycles.
注意事项
This product as supplied is intended for research use only, not for use in human, therapeutic or diagnostic applications.
数据库链接
产品介绍
GADD153蛋白与细胞凋亡和死亡密切相关,在某种程度上决定了细胞周期的进程。
背景资料
This gene encodes a member of the CCAAT/enhancer-binding protein (C/EBP) family of transcription factors. The protein functions as a dominant-negative inhibitor by forming heterodimers with other C/EBP members, such as C/EBP and LAP (liver activator protein), and preventing their DNA binding activity. The protein is implicated in adipogenesis and erythropoiesis, is activated by endoplasmic reticulum stress, and promotes apoptosis. Fusion of this gene and FUS on chromosome 16 or EWSR1 on chromosome 22 induced by translocation generates chimeric proteins in myxoid liposarcomas or Ewing sarcoma. Multiple alternatively spliced transcript variants encoding two isoforms with different length have been identified. [provided by RefSeq, Aug 2010].
Function : Multifunctional transcription factor in ER stress response. Plays an essential role in the response to a wide variety of cell stresses and induces cell cycle arrest and apoptosis in response to ER stress. Plays a dual role both as an inhibitor of CCAAT/enhancer-binding protein (C/EBP) function and as an activator of other genes. Acts as a dominant-negative regulator of C/EBP-induced transcription: dimerizes with members of the C/EBP family, impairs their association with C/EBP binding sites in the promoter regions, and inhibits the expression of C/EBP regulated genes. Positively regulates the transcription of TRIB3, IL6, IL8, IL23, TNFRSF10B/DR5, PPP1R15A/GADD34, BBC3/PUMA, BCL2L11/BIM and ERO1L. Negatively regulates; expression of BCL2 and MYOD1, ATF4-dependent transcriptional activation of asparagine synthetase (ASNS), CEBPA-dependent transcriptional activation of hepcidin (HAMP) and CEBPB-mediated expression of peroxisome proliferator-activated receptor gamma (PPARG). Inhibits the canonical Wnt signaling pathway by binding to TCF7L2/TCF4, impairing its DNA-binding properties and repressing its transcriptional activity. Plays a regulatory role in the inflammatory response through the induction of caspase-11 (CASP4/CASP11) which induces the activation of caspase-1 (CASP1) and both these caspases increase the activation of pro-IL1B to mature IL1B which is involved in the inflammatory response.

产品应用
| 应用 | 已检合格种属 | 预测种属 | 推荐稀释比例 |
|---|---|---|---|
| WB | Human, Mouse, Rat | 1:1000-2000 | |
| IHC-P | Human, Mouse, Rat | 1:100-500 | |
| IHC-F | Human, Mouse, Rat | 1:100-500 | |
| IF | Human, Mouse, Rat | 1:100-500 |
交叉反应
交叉反应: Human, Mouse, Rat
相关产品
暂无相关产品
靶标
基因名
DDIT3
蛋白名
DNA damage-inducible transcript 3 protein
亚基
Heterodimer. Interacts with TCF7L2/TCF4, EP300/P300, HDAC1, HDAC5 and HDAC6. Interacts with TRIB3 which blocks its association with EP300/P300. Interacts with FOXO3, CEBPB and ATF4.
亚细胞定位
Cytoplasm. Nucleus. Note=Present in the cytoplasm under non-stressed conditions and ER stress leads to its nuclear accumulation.
组织特异性
Ubiquitinated, leading to its degradation by the proteasome.
Phosphorylation at serine residues by MAPK14 enhances its transcriptional activation activity while phosphorylation at serine residues by CK2 inhibits its transcriptional activation activity
Phosphorylation at serine residues by MAPK14 enhances its transcriptional activation activity while phosphorylation at serine residues by CK2 inhibits its transcriptional activation activity
翻译后修饰
Ubiquitinated, leading to its degradation by the proteasome.
Phosphorylation at serine residues by MAPK14 enhances its transcriptional activation activity while phosphorylation at serine residues by CK2 inhibits its transcriptional activation activity.
Phosphorylation at serine residues by MAPK14 enhances its transcriptional activation activity while phosphorylation at serine residues by CK2 inhibits its transcriptional activation activity.
疾病
Note=A chromosomal aberration involving DDIT3 is found in a patient with malignant myxoid liposarcoma. Translocation t(12;16)(q13;p11) with FUS.
相似性
Belongs to the bZIP family.
Contains 1 bZIP (basic-leucine zipper) domain.
Contains 1 bZIP (basic-leucine zipper) domain.
功能
Inhibits the DNA-binding activity of C/EBP and LAP by forming heterodimers that cannot bind DNA.
同靶标产品
相关文献
提示: 发表研究结果有使用 bsm-52881R 时请让我们知道,以便我们可以引用参考文章。作为回馈,资料提供者将获得我们送上的小礼品。
具体参考文献:bsm-52881R 被引用于1文献中